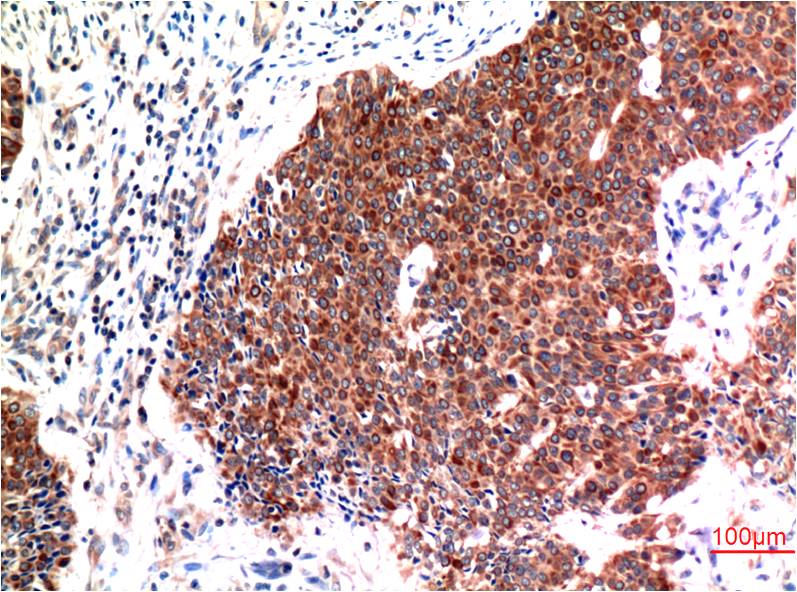
意大利贵宾会-贵宾会官方网站入口

ÕŠ«õ┐Īµē½õĖƵē½Ķ┐×Õ┐ÖÕÆ©Ķ»ó
ÕŠ«õ┐ĪńöĄĶäæń½»ÕÆ©Ķ»ó




 õĖĆķö«ÕżŹÕłČõ║¦Õōüõ┐Īµü»
õĖĆķö«ÕżŹÕłČõ║¦Õōüõ┐Īµü»| 50?L | ’┐ź1280.00 |
| 100?L | ’┐ź1980.00 |

Õģ│µ│©ÕŠ«õ┐ĪÕģ¼õ╝ŚÕÅĘ

ÕŠ«õ┐Īµē½õĖƵē½Ķ┐×Õ┐ÖÕÆ©Ķ»ó

ÕŠ«õ┐Īµē½õĖƵē½Ķ┐×Õ┐ÖÕÆ©Ķ»ó